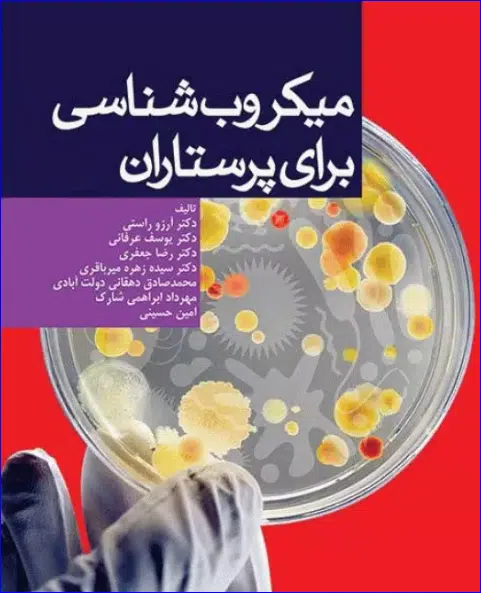

کتاب میکروبشناسی برای پرستاران
499.000 تومان قیمت اصلی: 499.000 تومان بود.409.180 تومانقیمت فعلی: 409.180 تومان.
-
ناشرجامعهنگر
-
شابک9786227684094
-
سال و نوبت چاپ سوم/1402
-
قطع وزیری
-
نوع جلدشومیز (جلد نرم)
-
تعداد صفحات252
-
وزن 400 گرم
دسته: جامعه نگر

دیدگاهها
هیچ دیدگاهی برای این محصول نوشته نشده است.